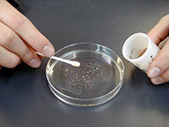
綿棒を使用した播胞

本校の生物部では創部以来46年間,「ラン科植物の無菌培養に関する研究」を継続して実施してきた。その研究の中で地元我孫子市産のシュンランや小笠原産の固有種で,絶滅危惧種に指定されているアサヒエビネの保護・増殖に関わり,無菌培養による発芽及び成長の後,自生地への植え戻しを実施してきた。
無菌培養の研究を継続する傍ら,ラン科植物と自生地の環境が類似しているシダ植物についての研究にも取り組み,小笠原産の固有種であるマルハチの前葉体形成に関する研究を実施した。この研究はシダ植物の胞子の発芽から前葉体形成に必要な条件について調べたものであり,教科書に記載されているシダ植物の生活環の授業に還元できると考え,今回この機会に紹介させていただくことにした。
【実験材料及び器具】
【手順】

【観察】
-マルハチの発芽から前葉体形成まで-

シダ植物の胞子を光学顕微鏡で観察したところ,色については緑色・褐色・黒褐色があり,形については正四面体と両面体が観察できた。このように,胞子の形と色を調べることである程度シダ植物を分類する手がかりになることが解った。


胞子の電子顕微鏡写真(NSEM)
シダ植物は生物基礎及び生物の教科書においてしばしば取り上げられているが,シダ植物を利用した実験・観察はほとんど実施されていないように思う。本校では生物の系統の中におけるシダ植物の生活環について授業を展開する際,予め発芽・成長をさせておいた材料を利用して観察を行っている。また,学習した内容が定着するよう,次のような内容のワークシートの作成を課題としている。
綿棒を使用した播胞

成長した前葉体
実験観察終了後,生徒たちから次のような感想を聴くことができた。
などがあった。
ヘゴのスケッチを見ると,発芽溝まで正確に描かれている。どの生徒も関心をもって実験観察に取り組むことができたと感じた。

生徒による胞子のスケッチ
本校周辺の里山ではベニシダをはじめ,イヌワラビなどが自生しており,胞子の形成される時期を知ることで一度に多くの胞子を採集することが可能である。これらの胞子はマルハチと同様の手順で発芽から前葉体形成までの各段階を観察することが可能である。しかし,スギナにおいては胞子内に葉緑素を含んでおり,採集後は数日しか発芽する能力がないため扱いづらい。また,最近はホームセンターなどでビカクシダをよく見かけるようになった。本校の温室でも栽培しているビカクシダは胞子を採集するため,10~12月頃に胞子葉に形成された胞子を胞子葉ごと切り取り,封筒に入れて乾燥させ,2週間後に封筒から葉を取りだして胞子を採集する。成長したビカクシダは複数の胞子葉を展開するため,一度に多くの胞子を採集することが可能で,実験観察の材料としては扱いやすい。

ビカクシダ(Platyceriumbifurcatum)

ビカクシダの胞子葉(裏側)
生物部員と共に実験・研究を重ねてきた結果が,このような形で授業に還元することができることを嬉しく感じている。現在,新型コロナウイルスの収束が未だに見込めない状況下において,理科室での実験も少なくなりがちである。しかし,生物の授業においてできることなら実物を観察させたいとの思いがあり,授業への還元を試みた。そのような折,原稿執筆の機会を頂き,試みをお伝えすることができたことに感謝します。